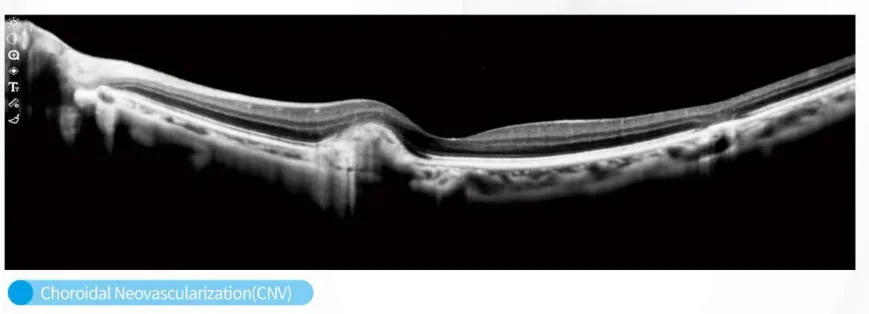
Hardware View 1

Product Overview
Velite C800 Intelligent OCT Diagnostic System
The Velite C800 CE-Certified Intelligent OCT Diagnostic System represents the new generation of ophthalmic imaging technology—engineered for precision, speed, and intelligent disease screening. Designed for modern eye-care institutions, it combines advanced AI algorithms with ultra-high-definition imaging to deliver accurate, reliable, and comprehensive diagnostic support within seconds.
Powered by an 86,000 A-Scan/second ultra-fast scanning engine, the C800 provides crystal-clear structural images with up to 8K/4K UHD resolution, enabling clinicians to detect early-stage abnormalities with exceptional clarity. Its integrated AI-assisted diagnostic platform offers automated analysis with up to 97% accuracy, dramatically enhancing workflow efficiency and reducing manual interpretation errors.
Advanced Clinical Capabilities
The C800 incorporates automatic eye-tracking, SLO scanning, and multi-mode tomographic imaging, ensuring stable visualization even for patients with difficulty maintaining fixation. Advanced choroidal thickness measurement and macular mapping support precise monitoring for myopia control, diabetic retinopathy, glaucoma, and age-related macular degeneration.
Built for intelligent healthcare, the system supports cloud-based data management, allowing remote consultation, multi-terminal data sharing, and seamless integration with hospital PACS systems. Its intuitive touch-screen interface enables faster examinations with minimal learning curve, making it suitable for both routine screening and advanced clinical use.
Frequently Asked Questions
What is the scanning speed of the Velite C800?
The system is powered by an ultra-fast scanning engine capable of performing ≥86,000 A-Scans per second, ensuring rapid and precise imaging.
How accurate is the AI diagnostic platform?
The integrated AI-assisted diagnostic system offers automated analysis with a clinical accuracy rate of up to 97% for various ophthalmic conditions.
Does the system support pediatric patients?
Yes, the diagnostic system is designed for all age groups, including children and adults, with features like automatic eye-tracking to assist patients who have difficulty focusing.
Can diagnostic data be shared or synced?
Yes, the system supports cloud-based data synchronization, allowing for remote consultation, multi-terminal data sharing, and seamless integration with hospital PACS systems.
What types of scanning modes are available?
The Velite C800 supports multiple modes including Line Scan, Grid Scan, and 3D Reconstruction to provide comprehensive tomographic imaging.
What clinical conditions can be monitored with this system?
It is ideal for monitoring and detecting myopia, diabetic retinopathy, glaucoma, and age-related macular degeneration through advanced choroidal and macular mapping.





 Pipmed Medical
Pipmed Medical